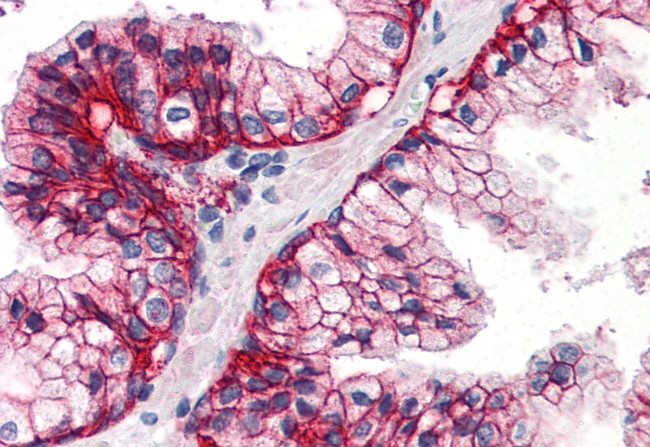
ASCT2 Antibody in Immunohistochemistry (Paraffin) (IHC (P))

Search
Invitrogen
ASCT2 Polyclonal Antibody
{{$productOrderCtrl.translations['antibody.pdp.commerceCard.promotion.promotions']}}
{{$productOrderCtrl.translations['antibody.pdp.commerceCard.promotion.viewpromo']}}
{{$productOrderCtrl.translations['antibody.pdp.commerceCard.promotion.promocode']}}: {{promo.promoCode}} {{promo.promoTitle}} {{promo.promoDescription}}. {{$productOrderCtrl.translations['antibody.pdp.commerceCard.promotion.learnmore']}}
产品信息
PA5-34201
种属反应
宿主/亚型
分类
类型
抗原
偶联物
形式
浓度
规格
纯化类型
保存液
内含物
保存条件
运输条件
RRID
产品详细信息
Percent identity with other species by BLAST analysis: Human (100%) Gibbon, Monkey, Rat (93%) Marmoset, Hamster, Elephant, Horse (87%) Mouse, Bat, Bovine (80%).
靶标信息
SLC1A5 (Solute carrier family 1 (neutral amino acid transporter), member 5) is a member of the Na(+)-dependent amino acid transporter superfamily. It has a broad substrate specificity, a preference for zwitterionic amino acids, and a sodium-dependence. It accepts as substrates all neutral amino acids, including glutamine, asparagine, and branched-chain and aromatic amino acids, and excludes methylated amino acids, anionic amino acids, and cationic amino acids. It acts as a cell surface receptor for feline endogenous virus RD114, baboon M7 endogenous virus and type D simian retroviruses.
仅用于科研。不用于诊断过程。未经明确授权不得转售。
篇参考文献 (0)
生物信息学
蛋白别名: Alanine/serine/cysteine transporter 2; ASC amino acid transporter-2; ASCT2; ATB(0); ATB0; Baboon M7 virus receptor; cell-surface receptor; neutral amino acid transporter; neutral amino acid transporter B; Neutral amino acid transporter B(0); RD114 virus receptor; RD114/simian type D retrovirus receptor; Sodium-dependent neutral amino acid transporter type 2; solute carrier family 1 (neutral amino acid transporter), member 5; Solute carrier family 1 member 5; unnamed protein product
基因别名: AAAT; ASCT2; ATBO; M7V1; M7VS1; R16; RDR; RDRC; SLC1A5
UniProt ID: (Human) Q15758
Entrez Gene ID: (Human) 6510